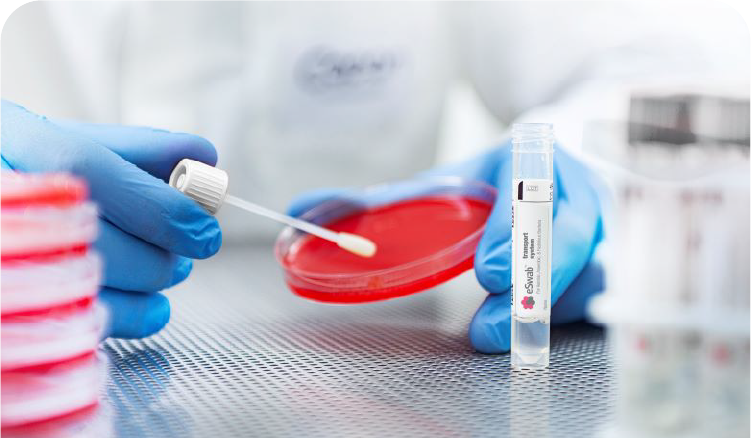

Clinical Diagnostic
Clinical Diagnostics focuses on detecting and monitoring diseases through laboratory testing of biological samples. We provide advanced diagnostic instruments and reagents that ensure accuracy, reliability, and efficiency empowering healthcare professionals to deliver better patient outcomes.